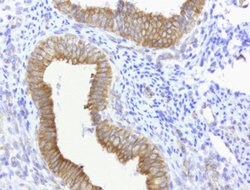

Promotional price valid on web orders only. Your contract pricing may differ. Interested in signing up for a dedicated account number?
Learn More
Learn More
CDH2 Mouse anti-Human, Clone: UMAB23, lyophilized, UltraMAB™


Mouse Monoclonal Antibody
Supplier: OriGene UM500023CF

Description
CDH2 encodes a classical cadherin and member of the cadherin superfamily. Alternative splicing results in multiple transcript variants, at least one of which encodes a preproprotein is proteolytically processed to generate a calcium-dependent cell adhesion molecule and glycoprotein. This protein plays a role in the establishment of left-right asymmetry, development of the nervous system and the formation of cartilage and bone.Specifications
| CDH2 | |
| Monoclonal | |
| Unconjugated | |
| CDH2 | |
| CD325, CDHN, CDw325, NCAD | |
| Mouse | |
| Affinity Chromatography | |
| RUO | |
| 1000 | |
| -20° C, Avoid Freeze/Thaw Cycles | |
| Lyophilized |
| Flow Cytometry, Immunohistochemistry (Paraffin), Western Blot | |
| UMAB23 | |
| PBS with 8% trehalose and no preservative | |
| P19022 | |
| CDH2 | |
| Full length human recombit protein of human CDH2 produced in HEK293T cell. | |
| 100 μg | |
| Primary | |
| Human | |
| Antibody | |
| IgG2a |
Product Content Correction
The Fisher Scientific Encompass Program offers items which are not part of our distribution portfolio. These products typically do not have pictures or detailed descriptions. However, we are committed to improving your shopping experience. Please use the form below to provide feedback related to the content on this product.
Product Title
Spot an opportunity for improvement?Share a Content Correction